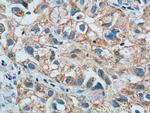
LONP1 Antibody in Immunohistochemistry (Paraffin) (IHC (P))

Search
Proteintech
LONP1 Monoclonal Antibody (1C6C12)
{{$productOrderCtrl.translations['antibody.pdp.commerceCard.promotion.promotions']}}
{{$productOrderCtrl.translations['antibody.pdp.commerceCard.promotion.viewpromo']}}
{{$productOrderCtrl.translations['antibody.pdp.commerceCard.promotion.promocode']}}: {{promo.promoCode}} {{promo.promoTitle}} {{promo.promoDescription}}. {{$productOrderCtrl.translations['antibody.pdp.commerceCard.promotion.learnmore']}}
产品信息
66043-1-IG
种属反应
已发表种属
宿主/亚型
分类
类型
克隆号
抗原
偶联物
形式
浓度
规格
纯化类型
保存液
内含物
保存条件
运输条件
产品详细信息
Immunogen sequence: EQNANFLDH YLDVPVDLSK VLFICTANVT DTIPEPLRDR MEMINVSGYV AQEKLAIAER YLVPQARALC GLDESKAKLS SDVLTLLIKQ YCRESGVRNL QKQVEKVLRK SAYKIVSGEA ESVEVTPENL QDFVGKPVFT VERMYDVTPP GVVMGLAWTA MGGSTLFVET SLRRPQDKDA KGDKDGSLEV TGQLGEVMKE SARIAYTFAR AFLMQHAPAN DYLVTSHIHL HVPEGATPKD GPSAGCTIVT ALLSLAMGRP VRQNLAMTGE VSLTGKILPV GGIKEKTIAA KRAGVTCIVL PAENKKDFYD LAAFITEGLE VHFVEHYREI FDIAFPDEQA EALAVER (614-959 aa encoded by BC000235 )
靶标信息
This gene encodes a mitochondrial matrix protein that belongs to the Lon family of ATP-dependent proteases. This protein mediates the selective degradation of misfolded, unassembled or oxidatively damaged polypeptides in the mitochondrial matrix. It may also have a chaperone function in the assembly of inner membrane protein complexes, and participate in the regulation of mitochondrial gene expression and maintenance of the integrity of the mitochondrial genome. Decreased expression of this gene has been noted in a patient with hereditary spastic paraplegia. Alternatively spliced transcript variants have been found for this gene.
仅用于科研。不用于诊断过程。未经明确授权不得转售。
生物信息学
蛋白别名: h LonHS; hLON ATP-dependent protease; Lon protease homolog, mitochondrial; lon protease homolog, mitochondrial {ECO:0000255|HAMAP-Rule:MF_03120}; Lon protease-like protein; lon protease-like protein {ECO:0000255|HAMAP-Rule:MF_03120}; LONHs; LONP; LONP {ECO:0000255|HAMAP-Rule:MF_03120}; Mitochondrial ATP-dependent protease Lon; mitochondrial ATP-dependent protease Lon {ECO:0000255|HAMAP-Rule:MF_03120}; mitochondrial lon protease-like protein; protease, serine, 15; Serine protease 15; serine protease 15 {ECO:0000255|HAMAP-Rule:MF_03120}; unnamed protein product
基因别名: 1200017E13Rik; CODASS; hLON; LON; LonHS; LONP; LONP1; PIM1; PRSS15
UniProt ID: (Human) P36776, (Mouse) Q8CGK3, (Rat) Q924S5
Entrez Gene ID: (Human) 9361, (Mouse) 74142, (Rat) 170916